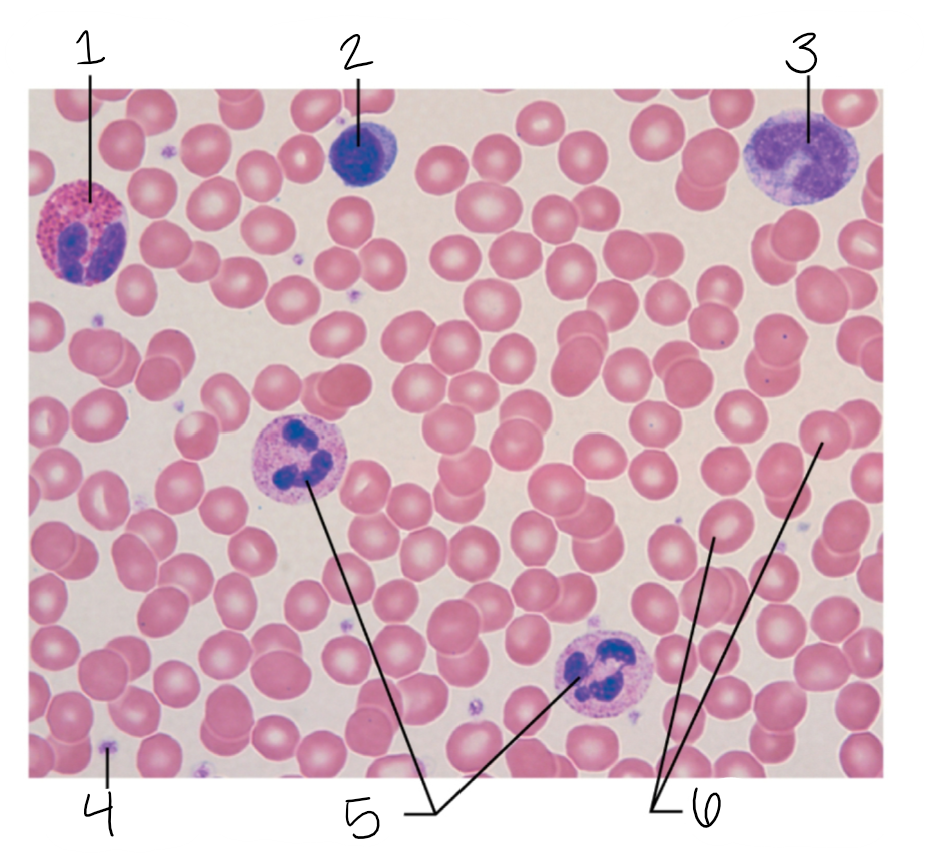

Formed Elements
1/12
There's no tags or description
Looks like no tags are added yet.
Name | Mastery | Learn | Test | Matching | Spaced |
|---|
No study sessions yet.
13 Terms
neutrophils
bacteria, defensins, chronic illnesses
some contain hydrolytic enzymes and are regarded as lysosomes
eosinophils
lysosome-like, but lack enzymes that specifically digest bacteria
counterattack against parasitic worms that are too large to be phagocytized
have complex roles in other diseases including allergies and asthma
basophils
cytoplasm contains large, coarse, histamine-containing granules
lymphocytes
vital for immunity
T and B cells
monocytes
differentiate into highly mobile macrophages
phagocytic and are crucial in the body’s defense against viruses, certain intracellular bacterial parasites, and chronic infections such as tuberculosis
platelets
aid in forming a temporary plug in blood clotting
red blood cells
transport O2 and CO2
eosinophil
1

lymphocyte
2

monocyte
3

platelet
4
neutrophils
5

erythrocytes
6
